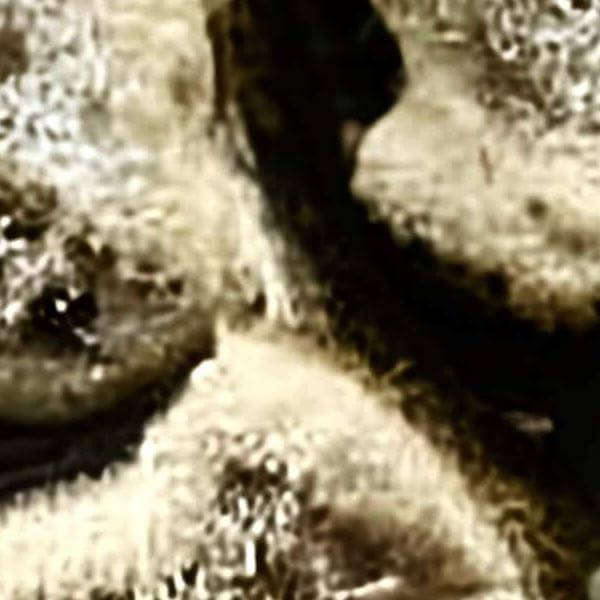

|

|

|

|

|

|
Various images were created by AI
AI artworks > Various patterns learned > Microorganism and viruses learned > Microorganism and viruses negativeAI Artwork: 「微生物の否認」
Reduced image (600×600)

The high-precision poster of this image can be purchased at a page in Rakuten or a page in Yahoo! Shopping by inputting the image ID. This image can be downloaded as a PDf file.
How to create images?
This image was created by ‘anonymous,’ an art unit formed by the creator and the AI (Stable Diffusion 2.1 (768), a program for creating AI artworks). I gave the program the word ‘microorganism’ as a prompt and let it create. Also “microorganism” was used as the negative prompt.
In AI art, the images generated are usually quite rough—about the size of an A6 print (roughly 500–1000 pixels on each side). To make them suitable for presentation, I use a technique called super-resolution, which increases the resolution 4–8 times higher than the original, adding finer detail. However, please note that the resolution of the product image shown above is about the same as the original and has not been upscaled.
These images are created by our original method, which is different from usual AI art images. AI art images are created by giving English description called prompt. Many AI art images were created by using AI art programs such as Stable Diffusion,DALL・E 2,or Midjourney in 2022. To create expected images by AI art, a detailed description is usually given. However, we usually give only a few words or a coined word to web sites of OpenArt, NightCafe, etc., which use Stable Diffusion 2.1 (768); That is, the program create images generatively and emergently using the knowledge of the program freely. The contrast of created images are adjusted, but they were not modified.
Unintentional images created in this way are also called "AI art", but I don't think they are necessarily art. However, there are unexpected images or images with a style different from that of the work, patterns, or Various interesting images such as cats embedded in stained glass can be created. Images created by this method, i.e., unintended iamges, are to be called "AI art",
Keywords
AI art, AI artist, Image generator AI, Artificial intelligence art, Computer art, Digital art, Media art, Stable Diffusion, Generative art, Emergent, Art generator, Intelior, Wall art, Art poster, Art print, Original poster
Note on copyright
This image was generated by AI using the ISAP method. It is not intended to imitate or reproduce any specific living artist or existing artwork. If you notice anything of concern, please contact us at info@dasyn.com .
Dasyn.com デイシン
2026-01-16 22:07:52.625932